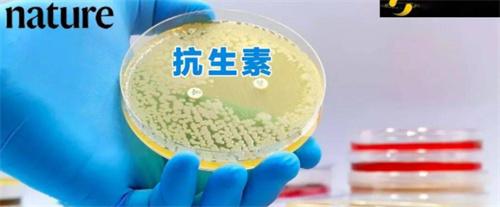

2016-2022 All Rights Reserved.平安財經(jīng)網(wǎng).復制必究 聯(lián)系QQ 備案號:
本站除標明“本站原創(chuàng)”外所有信息均轉(zhuǎn)載自互聯(lián)網(wǎng) 版權歸原作者所有。
郵箱:toplearningteam#gmail.com (請將#換成@)
最新發(fā)現(xiàn)的抗生素是用來對抗金黃色葡萄球菌,近日,MIT的科學家使用ai系統(tǒng)發(fā)現(xiàn)了一種全新的抗生素,這種抗生素主要可以對抗耐藥性的金黃色葡萄球菌,這是人類60年以來第一批能夠用于金黃色葡萄酒菌的新抗生素,該抗生素的出現(xiàn),也標志著人類在抗生素研究方面取得了重要的進展,不過該領域的空白是人類在AI的輔助下突破的。
據(jù)了解,MIT的科學家團隊總共有21名研究者共同撰寫了一篇論文,在這篇論文當中指出,新發(fā)現(xiàn)的這種抗生素是一種可解釋的圖神經(jīng)網(wǎng)絡,通過在上百萬個化合物中篩選,總共測試了283種有前景的化合物,發(fā)現(xiàn)其中部分化合物對mrsa有治療效果,該消息傳出之后,眾多AI行業(yè)的大佬紛紛轉(zhuǎn)發(fā)了這一重磅發(fā)現(xiàn)。
2016-2022 All Rights Reserved.平安財經(jīng)網(wǎng).復制必究 聯(lián)系QQ 備案號:
本站除標明“本站原創(chuàng)”外所有信息均轉(zhuǎn)載自互聯(lián)網(wǎng) 版權歸原作者所有。
郵箱:toplearningteam#gmail.com (請將#換成@)